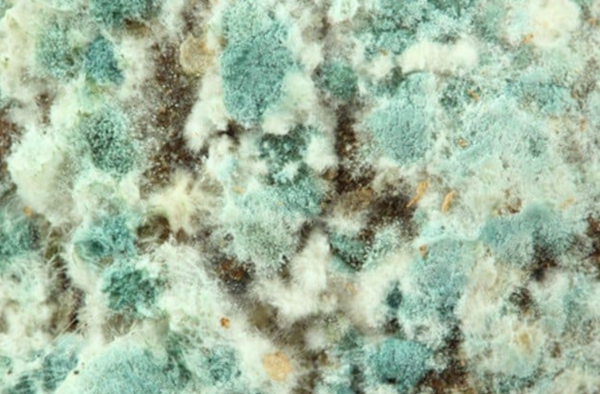

Skimmelsvamp er et alvorligt problem i mange danske boliger og kan have store sundhedsmæssige konsekvenser. Men hvor farligt er skimmelsvamp egentlig, og hvor mange mennesker dør årligt som følge af skimmelsvamprelaterede sygdomme? Selvom det er svært at give et præcist tal, da dødsfald sjældent tilskrives skimmelsvamp alene, men ofte sammen med andre helbredsproblemer, er der stærke indikationer på, at skimmelsvamp kan være en medvirkende faktor til alvorlige luftvejslidelser, infektioner og i værste fald død.
Hvor farlig er skimmelsvamp?
Skimmelsvamp producerer sporer og giftstoffer, der kan påvirke luftvejene og immunsystemet. Dette kan føre til symptomer som hoste, træthed, hovedpine, allergiske reaktioner og åndedrætsbesvær. Personer med astma, KOL eller svækket immunforsvar er særligt udsatte, da skimmelsvamp kan forværre deres tilstand. Ny forskning tyder på, at langvarig eksponering for skimmelsvamp kan øge risikoen for udvikling af kroniske lungesygdomme og endda bidrage til tidlig død.
En rapport fra WHO har peget på, at dårlig indeklima, herunder skimmelsvamp, er forbundet med øget sygelighed og dødelighed i hele verden. I Danmark er det estimeret, at tusindvis af mennesker hvert år udvikler alvorlige sygdomme som følge af fugt og skimmel i boligen, hvilket kan føre til dødsfald i særligt alvorlige tilfælde.
Hvordan undgår man skimmelsvamp?
For at minimere risikoen for skimmelsvamp er det vigtigt at have et godt indeklima. Her er nogle af de vigtigste forholdsregler:
Ventilation: Sørg for at lufte ud mindst tre gange dagligt i 5-10 minutter ad gangen. Dette hjælper med at reducere fugt i luften og forbedrer luftcirkulationen.
Hold fugtniveauet nede: Undgå at tørre tøj indenfor uden en tørretumbler med aftræk, og brug emhætte ved madlavning for at reducere dampen i luften.
Tjek for vandskader: Lækager fra tage, rør og vægge bør udbedres hurtigt for at forhindre fugtskader, der kan føre til skimmelsvamp.
Brug affugtere i fugtige rum: I kældre og andre områder med høj luftfugtighed kan en affugter hjælpe med at holde niveauet nede.
Undgå kuldebroer: Dårligt isolerede boliger kan danne kolde overflader, hvor kondens opstår, hvilket giver optimale vækstbetingelser for skimmelsvamp.
Kan man teste for skimmelsvamp?
Ja, det er muligt at teste for skimmelsvamp, hvis man mistænker, at ens bolig er angrebet. Der findes forskellige testmetoder afhængigt af om det er synlig eller usynlig skimmelsvamp, der skal testses for. Derudover findes der forskellige kvaliteter. Det spænder lige fra billige indikationsskimmelsvamptests til professionelle skimmelsvamptests.
Fælles er det dog at man sagtens som privatperson kan teste. Der behøves ikke at komme en "skimmelekspert" ud for testdelen.
Afsluttende kommentar
Skimmelsvamp er ikke blot en kosmetisk gene – det kan være en alvorlig sundhedstrussel, som potentielt kan bidrage til dødsfald hos sårbare grupper. For at undgå skimmelsvamp er det vigtigt at holde boligen tør, ventilere korrekt og reagere hurtigt på fugtskader. Hvis man er i tvivl, kan man teste for skimmelsvamp og tage nødvendige skridt for at fjerne den. Har man mistanke om skimmel i sit hjem, kan man nemt teste det med en skimmelsvamptest, som giver en præcis vurdering af problemet.